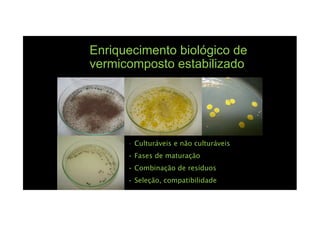
Enriquecimento biológico de
vermicomposto estabilizado
• Culturáveis e não culturáveis
• Fases de maturação
• Combinação de resíduos
• Seleção, compatibilidade
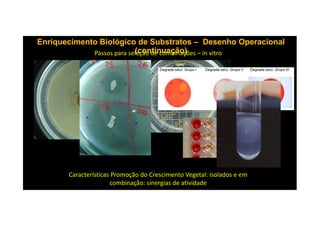
Enriquecimento Biológico de SubstratosEnriquecimento Biológico de Substratos –– Desenho OperacionalDesenho Operacional
(continuação)(continuação)Passos para seleção de combinações – in vitro
Características Promoção do Crescimento Vegetal: isolados e em
combinação: sinergias de atividade

O documento discute o potencial dos processos microbianos como insumos biológicos para uma agricultura sustentável. Apresenta estratégias para melhor aproveitar microrganismos a favor do crescimento vegetal, como a inoculação de bactérias promotoras ou a ativação de comunidades nativas pelo manejo do solo e da planta. Também descreve estudos sobre biofertilizantes produzidos a partir da combinação de ácidos húmicos e bactérias diazotróficas, que promovem alterações morfológicas